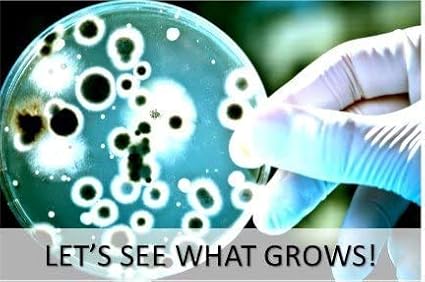

1
/
의
9
Diamante+Scientific
Essential 2.0 Bacteria Growing Science Kit. Pre-Poured Agar Plates (100mm) with Gloves & Swabs. Perfect for Kids. Great for Learning About Microbiology. Free Project Guide eBook Available.
Essential 2.0 Bacteria Growing Science Kit. Pre-Poured Agar Plates (100mm) with Gloves & Swabs. Perfect for Kids. Great for Learning About Microbiology. Free Project Guide eBook Available.
정가
$23.45 USD
정가
할인가
$23.45 USD
수량
픽업 사용 가능 여부를 로드할 수 없습니다.
About This
- ONE OF THE BEST SELLING BACTERIA GROWING SCIENCE FAIR KITS. Each kit includes 10 - 100mm pre-poured agar plates, 10 - 6" sterile cotton swabs, one pair of gloves, simple step-by-step instructions and a free science experiment project guide
- OUR PLATES ARE PRE-POURED. DON'T WASTE TIME POURING AGAR. GET RIGHT TO GROWING BACTERIA. The plates are pre-poured, TS (Tryptic Soy) Agar. The same nutrient agar used by microbiologists to grow bacteria in the lab. It's perfectly safe for kids when you follow the instructions. You don’t have to pour your own plates which can be time-consuming and sometimes dangerous for kids. These plates are the perfect size for school-aged kids for use in science class.
- OUR PLATES ARE MANUFACTURED IN THE USA. They have a thick layer of agar which promotes good growth and have been professionally packaged under strict conditions.
- GREAT FOR ENCOURAGING (STEM) SCIENCE, TECHNOLOGY, ENGINEERING, MATHMATICS FOR YOUNG STUDENTS. Ideal for elementary, middle school and high school students. Recommended for age 8 and up with adult supervision.
- FREE SCIENCE EXPERIMENT PROJECT GUIDE. Contains easy to follow instructions, experiments and ideas to get the most out of your science kit. When you purchase our kit, you can call or email our knowledgeable staff with any questions. Please visit our website and follow us on Facebook and Twitter. DIAMANTE SCIENTIFIC OFFERS OTHER GREAT SCIENCE KITS FOR KIDS LIKE BUILDING A MINIATURE TERRARIUM AND GROWING CRYSTALS.
Share